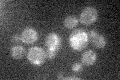
YMR115W
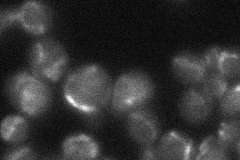
YMR115W
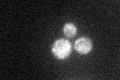
YMR115W
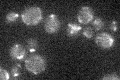
YMR115W

View description
Subunit of the mitochondrial (mt) i-AAA protease supercomplex, which degrades misfolded mitochondrial proteins; forms a subcomplex with Mgr1p that binds to substrates to facilitate proteolysis; required for growth of cells lacking mtDNA
Localization:
Intensity:
Fold change:
Significance:
-
C’ GFP library in SD
mitochondria19.91 -
N' NOP1pr-GFP in SD

mitochondria106.544 -
N' TEF2pr-mCherry in SD

mitochondria79.738 -
N' NATIVEpr-GFP in SD
mitochondria27.4562 -
N' TEF2pr-VC and Cyto-VN in SD

#N/A0 -
C’ GFP library in SD+DTT
mitochondria21.721.09No -
C’ GFP library in SD+H2O2

mitochondria17.840.89No -
C’ GFP library in Starvation Media
mitochondria18.60.93No -
C’ GFP library on the background of Pup2-DaMP

mitochondria -
C’ GFP library on the background of CCT mutant

mitochondria22.64491.13675No
